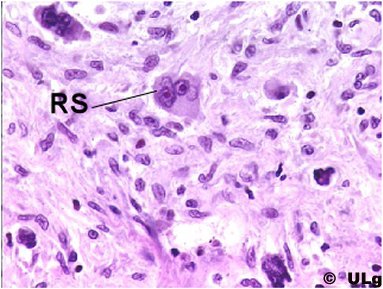

Lymphome hodgkinien
| Cliquer sur le bouton ci-contre pour imprimer cette page, sinon utiliser la commande 'Imprimer' ou 'Print' de votre navigateur |
Exemple de tumeur maligne dérivée du tissu lymphoďde
Tissu pathologique: tumeur modérément cellulaire qui se développe au niveau d’un ganglion lymphatique dont l’architecture a disparu et qui envahit la graisse péri-ganglionnaire (G). Le sinus (S) marginal du ganglion lymphatique est encore reconnaissable par endroits. Présence de cellules de grande taille déjŕ visibles au faible grossissement
Tissu pathologique: présence de grandes cellules, au noyau irrégulier, plissé, habituellement bilobé ou plurilobé, ŕ chromatine irréguličre ponctuée par un ou plusieurs nucléoles acidophiles et centraux correspondant ŕ des cellules de Hodgkin et ŕ des cellules de Reed-Sternberg (noyaux se faisant face "en miroir") (RS). Ces cellules se disposent au sein d’un tissu d’aspect fibreux et se męlent ŕ de rares lymphocytes d’aspect normal
 |
|